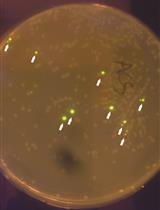
Assembly of Genetic Circuits with the Mammalian ToolKit

- Protocols
- Articles and Issues
- About
- Become a Reviewer
Past Issue in 2020
Volume: 10, Issue: 5
Biochemistry
Assembly of Genetic Circuits with the Mammalian ToolKit
Production, Purification and Characterization of Recombinant Biotinylated Phytochrome B for Extracellular Optogenetics
Manganese Superoxide Dismutase Activity Assay in the Yeast Saccharomyces cerevisiae
Developmental Biology
Lipid Mixing Assay for Murine Myoblast Fusion and Other Slow Cell-cell Fusion Processes
Immunology
Optogenetic Tuning of Ligand Binding to The Human T cell Receptor Using The opto-ligand-TCR System
Zebrafish Bacterial Infection Assay to Study Host-Pathogen Interactions
Microbiology
Contemporaneous Measurement of Outer and Inner Membrane Permeability in Gram-negative Bacteria
Growth Recovery Assay and FACS-based Population Sorting Following Territorial Exclusion in Proteus mirabilis
Molecular Biology
Cell-free Reconstitution of the Packaging of Cargo Proteins into Vesicles at the trans Golgi Network
Neuroscience
Delayed Alternation Task for the Study of Spatial Working and Long Term Memory in Rats
Plant Science
Tandem Tag Assay Optimized for Semi-automated in vivo Autophagic Activity Measurement in Arabidopsis thaliana roots
Quantification of Protein Enrichment at Plasmodesmata
Insect Feeding Assays with Spodoptera exigua on Arabidopsis thaliana
Single-run HPLC Quantification of Plant Cell Wall Monosaccharides
Systems Biology
mRNA Extraction from Gill Tissue for RNA-sequencing